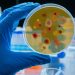
Νέο φάρμακο κατά της ελονοσίας με ισχυρά αποτελέσματα — ελπίδα κατά της ανθεκτικότητας

Μια πρόσφατη μετα-ανάλυση που καλύπτει 96 μελέτες από 21 χώρες και πάνω από 443.000 παιδιά και εφήβους δείχνει ότι η παγκόσμια συχνότητα της υπέρτασης σε ηλικίες έως 19 ετών σχεδόν διπλασιάστηκε μεταξύ 2000 και 2020 — από περίπου 3,2 % το 2000 σε πάνω από 6,2 % το 2020.
Η έρευνα επισημαίνει ότι η παιδική παχυσαρκία είναι ένας από τους πιο ισχυρούς παράγοντες: περίπου 19% των παιδιών και εφήβων με παχυσαρκία εμφάνισαν υπέρταση, συγκριτικά με κάτω του 3 % μεταξύ των παιδιών με υγιές βάρος.
Οι ερευνητές ξεχωρίζουν επίσης το φαινόμενο της «masked» υπέρτασης (υπέρταση που δεν ανιχνεύεται σε τυπικό ιατρικό έλεγχο), όπου υπολογίζεται ότι περίπου 9,2 % των παιδιών μπορεί να επηρεάζονται — γεγονός που δείχνει ότι η πραγματική συχνότητα ενδέχεται να είναι ακόμη υψηλότερη.
Το άρθρο προειδοποιεί ότι η τακτική μέτρηση της πίεσης στα παιδιά και εφήβους — ειδικά σε ηλικίες όπου η αρτηριακή πίεση ανεβαίνει (γύρω στα 14 έτη) — γίνεται όλο και πιο απαραίτητη, καθώς η υπέρταση στην παιδική ή εφηβική ηλικία μπορεί να προδιαθέσει σε καρδιαγγειακές νόσους, νεφρική βλάβη και άλλες μακροχρόνιες επιπλοκές στην ενήλικη ζωή.
Οι συγγραφείς υπογραμμίζουν ότι η αύξηση αυτή «πρέπει να ηχήσει ως καμπανάκι» για παιδίατρους, γονείς και υπεύθυνους δημόσιας υγείας. Παράλληλα, σημειώνουν ότι, ενώ υπάρχουν μέτρα πρόληψης (όπως υγιεινή διατροφή, τακτική σωματική δραστηριότητα, περιορισμός καθιστικής συμπεριφοράς / οθονών), απαιτείται επανασχεδιασμός πολιτικών υγείας ώστε να ενσωματωθούν συστηματικοί έλεγχοι της πίεσης και προγράμματα πρόληψης στην σχολική ηλικία.
Συνοψίζοντας: η τάση είναι σαφής — η υπέρταση σε παιδιά και εφήβους αυξάνεται, κυρίως λόγω αλλαγών στον τρόπο ζωής και αύξησης της παιδικής παχυσαρκίας. Η έγκαιρη ανίχνευση και αντιμετώπιση μπορεί να αποτρέψει πολλές μελλοντικές επιπλοκές.
Πηγή: «High blood pressure in children nearly doubled from 2000–2020, global study finds», Medical Xpress